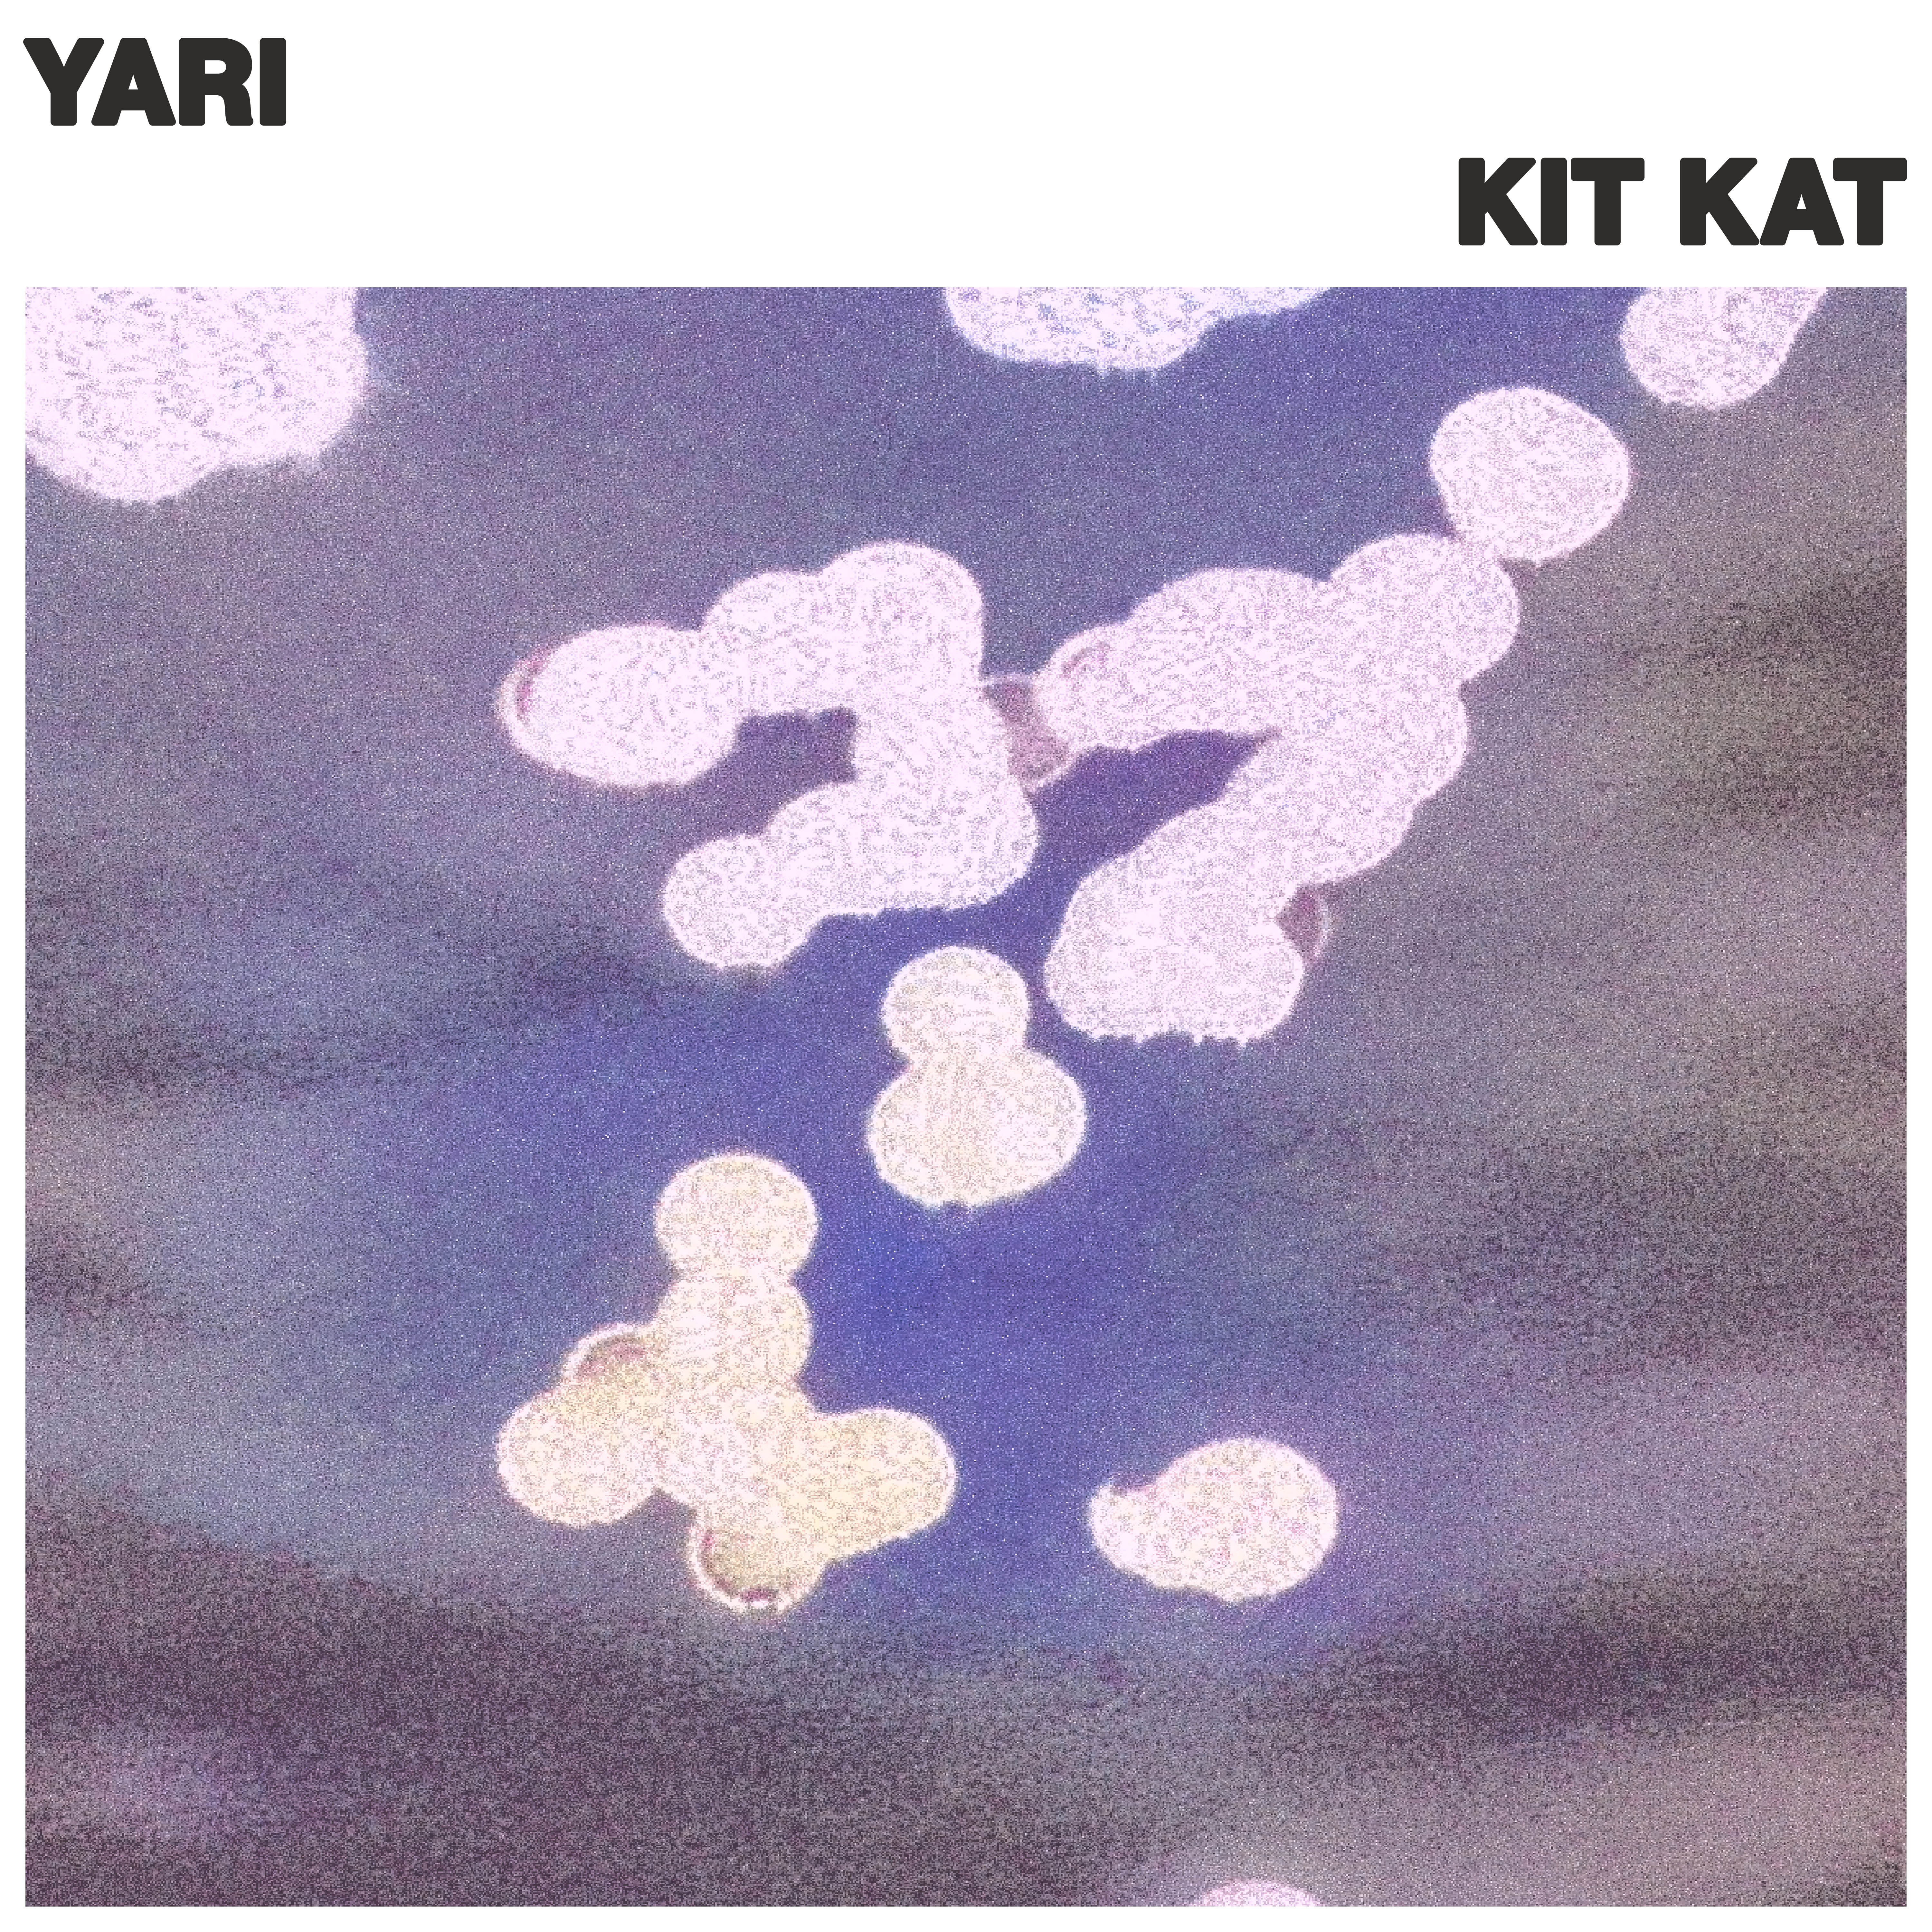

KIT KAT by YARI
Tracklist
1. | Kit Kat | 4:54 |
Credits
released May 16, 2025
License
All rights reserved.Recommendations

by Fredih

by KI/KI

by Minus Magnus

by Invisible Squirrel

by Invisible Squirrel

by James Holden
by Courtesy